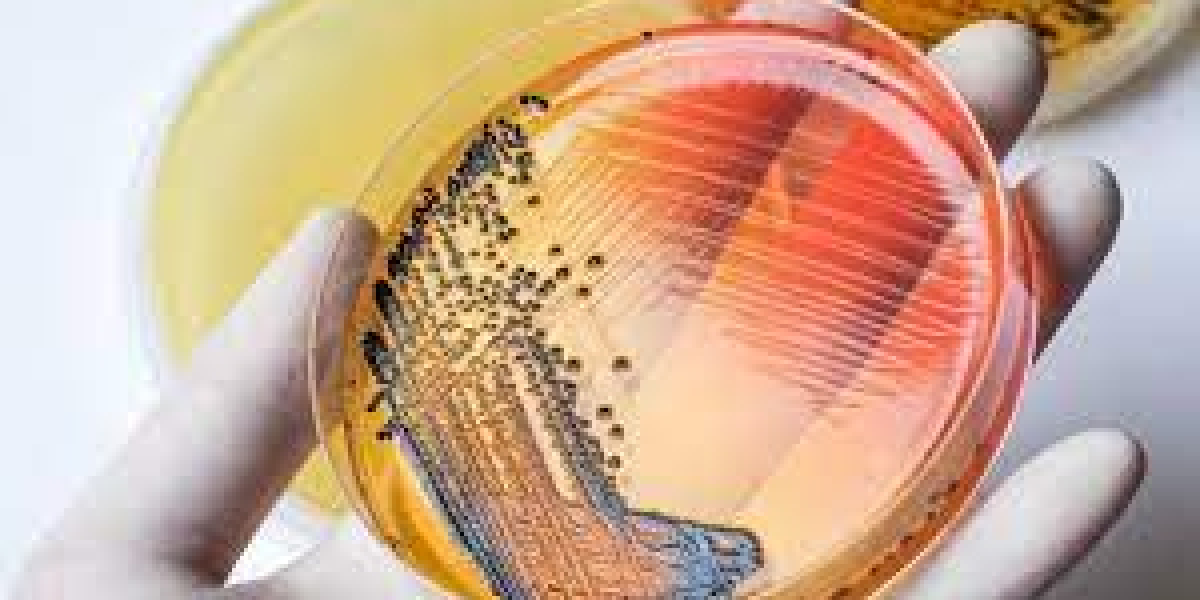
Enteric Disease Testing Market 2023 Industry Development, Analysis of Driving Factors and Growth Forecast to 2030

Prima Weight Loss Ireland:- Also, this routine is the most ideal choice for diminishing overabundance body weight normally.
Official Reviews : https://www.outlookindia.com/outlook-spotlight/dragons-den-prima-weight-loss-pills-ireland-uk-prima-weight-loss-capsules-check-limited-offer-before-buy--news-219664
https://healthcare24hrs.com/prima-weight-loss-ie/
Facebook Page : https://www.facebook.com/primaweightlossIE
Facebook Page : https://www.facebook.com/Prima.Weight.Loss.Ireland.Ie
Facebook Page : https://www.facebook.com/PrimaWeightLossTablets.UK.Ireland/
Facebook Page : https://www.facebook.com/PrimaWeightLossTablets/
Facebook Page : https://www.facebook.com/FigurHohleDerLowen.DE/
Facebook Page : https://www.facebook.com/FigurKapselnErfahrungen/
Facebook Page : https://www.facebook.com/FigurWeightloss
Facebook Page : https://www.facebook.com/FigurWeightlossInUK/
Facebook Page : https://www.facebook.com/FigurSlimmingTabletsUK
Facebook Page : https://www.facebook.com/FigurWeightLossDragonsDenUK/
Facebook Page : https://www.facebook.com/FigurweightLossDragonsDen/
Facebook Page : https://www.facebook.com/FigurWeightLossTablets/
Facebook Page : https://www.facebook.com/ViaketoCapsulesAustralia/
Facebook Page : https://www.facebook.com/LetsKetoCapsulesAU
https://prima-weight-loss-ireland.jimdosite.com/
https://prima-weight-loss-ireland-8.jimdosite.com/
https://sites.google.com/view/prima-weight-loss-ire-land/
https://groups.google.com/u/1/g/prima-weight-loss-ire-land/c/fy8572O9RiA